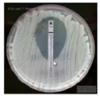

Akut mikrobiologi Flashcards
(16 cards)
Fall 1
- Bakgrund
- Kvinna, 73 år, frisk och medicinfri, tidigare rökare men slutat för ett år sen. En vecka hosta, succesivt sämre, orkar inte ta sig till vårdcentral. Ambulans hämtar henna. Blåa fingrar/cyanotisk, lite blå om läpparna
- Prover på akuten
- LPK högt
- CRP 293
- Laktat 3,8 (tecken på nedsatt cirkulation)
- Blodgas: 83 % på 15 liter syrgas
- Ha lite observandum på blodtrycket (hos ung person är det kanske mer rimligt)
Arbetsdiagnos?

- Infektion, sepsis
Lämpligt provmaterial/provlokal luftvägar?
- Sputum (representerar nedre luftvägar) bättre än nasofarynx
- Trakealsekret och BAL kan tas hos någon som är intuberad
- Urinprov

Lämpligt provmaterial vid sepsisdiagnostik?
- Blod
- Urin
- Vid misstänkt fokus (ex sår)

Remissen till labb viktig!
Vad kan vara viktigt att det står på remissen?
- Detta eftersom ovan påverkar hur provet tas omhand på labbet
- Även hur ev fynd bedöms/tolkas
- Symptombild (kortfattat), ev immunosupression, protes (viktigt då de kan leta efter mer ovanliga agens)
- Hur länge har patienten varit sjuk? (serologiska prover)
- Ev utlandsvistelse?
- Pågående/planerad antibiotika (resistenstesta)
Luftvägar (sputum/nasofarynxprov, trakealsekret/bronksköljvätska, urin)
-
Odling
- Bakterier, svamp
På vilka olika sätt kan vi odla och vad får vi fram?
- MALDI-ToF (Art)
- Snabb enkel artbestämning av bakterier och svamp
- Ger en bild av de molekyler som finns i organismen (proteiner/peptider/sockerarter)
- Jämförs med spektrum på olika arter
- VITEK (Art och resistens)
- Bakteriekolonier inkuberas på chip med olika brunnar, oftast jäsning av sockerarter (ex vi vet att E. coli jäser denna sockerart på ett visst sätt), även resistens mot vissa antibiotika
- Brunnar och vi kan få mönster på som är specifika för olika arter, även resistensbestämning
- Diskdiffusion (resistens)
- Bakterier odlas ut och diskar med antibiotika tillsätts och sedan mäts zonen runt antibiotikadisken – större zon = mer känslig bakterie
- E-test (MIC) (resistens), strip läggs på i fallande koncentration

Vad visar bilden?
- E-test (MIC) (resistens), strip läggs på i fallande koncentration
Luftvägar (sputum/nasofarynxprov, trakealsekret/bronksköljvätska, urin)
För och nackdelar med PCR?
- Snabbt svar
- Bred diagnostik
- Även svårodlade agens (virus, intracellulära bakterier)
- Vi kan leta efter specifik agens eller multiplex mot flera agens (ex luftvgägsblock)
- Men vi får ingen resistensbestämning (odling och PCR kompletterar därför varandra)
Luftvägar (sputum/nasofarynxprov, trakealsekret/bronksköljvätska, urin)
Vad kan vi göra med urinprovet utöver att odla?
- Snabbtest för bakterieantigen – antigendetektion med immunkromatografi (med hjälp av antikroppar)
- Streptococcus pneumoniae
- Legionella pneumophila sg1
Hur många rör tar vi och vad tittar vi på vid blododling?
- Görs x2, aerob (2 st) och anaerob (2 st)
- Inkubering och gramfärgning – G+ och G-
- Artbestämning (MALDI-ToF oftast) och resistensbestämning
Behandling svår pneumoni innan vi har fått svar?
- Bred behandling först
- Cefotaxim 2g X3 + extrados
- Erytromycin 1g x3 (täcker in även mer atypiska som legionella etc)
Fall 2
Man 65 år, frisk och medicinfri. Lantbrukare. 4 dygn med huvudvärk och hög feber. Dubbelseende. Söker därför vårdcentralen. Ataxi vid finger-näs. Remitteras till akutmottagningen
- Status
- Fullt orienterad
- Fullständigt neurostatus visar lite svajighet i gångmönster och Grassets test tendens till pronation
- Prover och tester
- Normala blodprover och CT-hjärna
-
Likvoranalys
- Mononukleära leukocyter talar för virus även bakterien borrelia och listeria
- Albumin förhöjt – tecken på BBB-skada
-
Övrigt
- Inga blåsor på kroppen
- Inga resor
- Kraftig fästingexponering
- Lantbrukare och område med känd förekomst av TBE
Arbetsdiagnos?
- Meningit/encefalitdiagnostik
Mikrobiologisk diagnostik
- Arbetsdiagnos
- Meningit/encefalitdiagnostik
Lämpligt provmaterial/provlokal?
- Cerebrospinalvätska genom lumbalpunktion
På vilka sätt kan vi analysera cerebrospinalvätska och vad är bra att komplettera med?
- Odling för bakterier och resistensbestämning
- PCR
- Snabbt svar
- Bred diagnostik
- Även svårodlade agens
- Serologi
- Indirekt detektion (ak)
- Svårfångade agens
- Samtidigt serumprov
Blododling (det kan ju vara bakterie), samma som ovan för att se var de kommer ifrån

Grundprincip för serologisk diagnostik? Vilka olika typer finns det?
- Kan designas på olika sätt
- Bygger på bindningar mellan antikroppar (kroppens IgM ex) och antigen – princip till höger.
- ELISA (kvantitativ)
- Mäter oftast mot ett antigen
- Immunoblot (kvalitativ)
- Multiplex bead array (kvant + kval)
- ELISA (kvantitativ)

Begränsningar med serologi?
- Det tar tid att bilda antikroppar
- Antikroppar finns kvar långt efter infektionen (ffa IgG)
- Osepcifika antikropps-antigenbindningar i tester (ffa IgM och större problem i serum än CSV)
När kan denna provsamling eventuellt ses?

Misstänkt infektion (svår) i luftvägar


